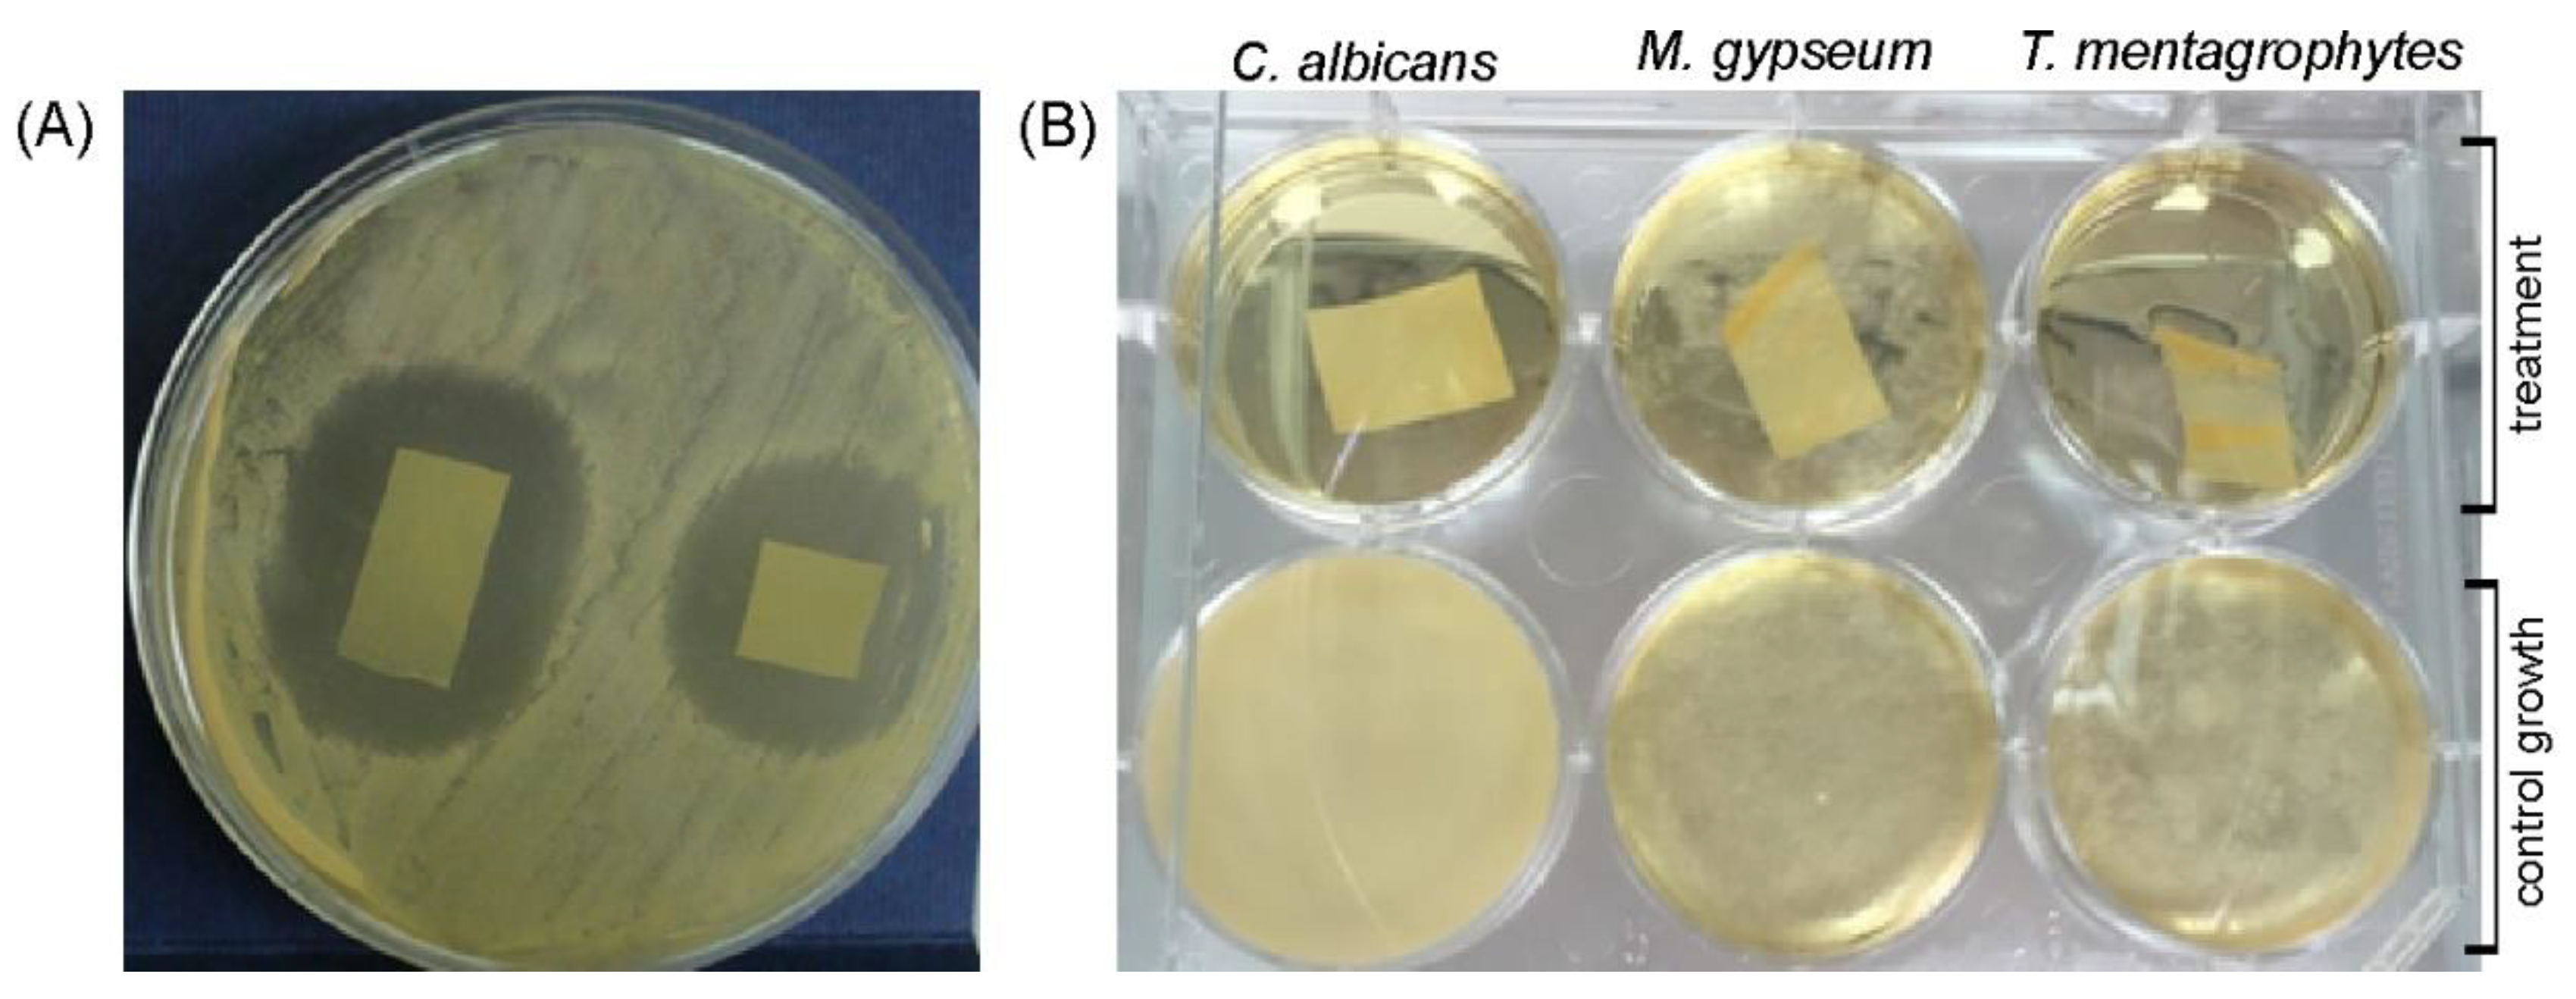
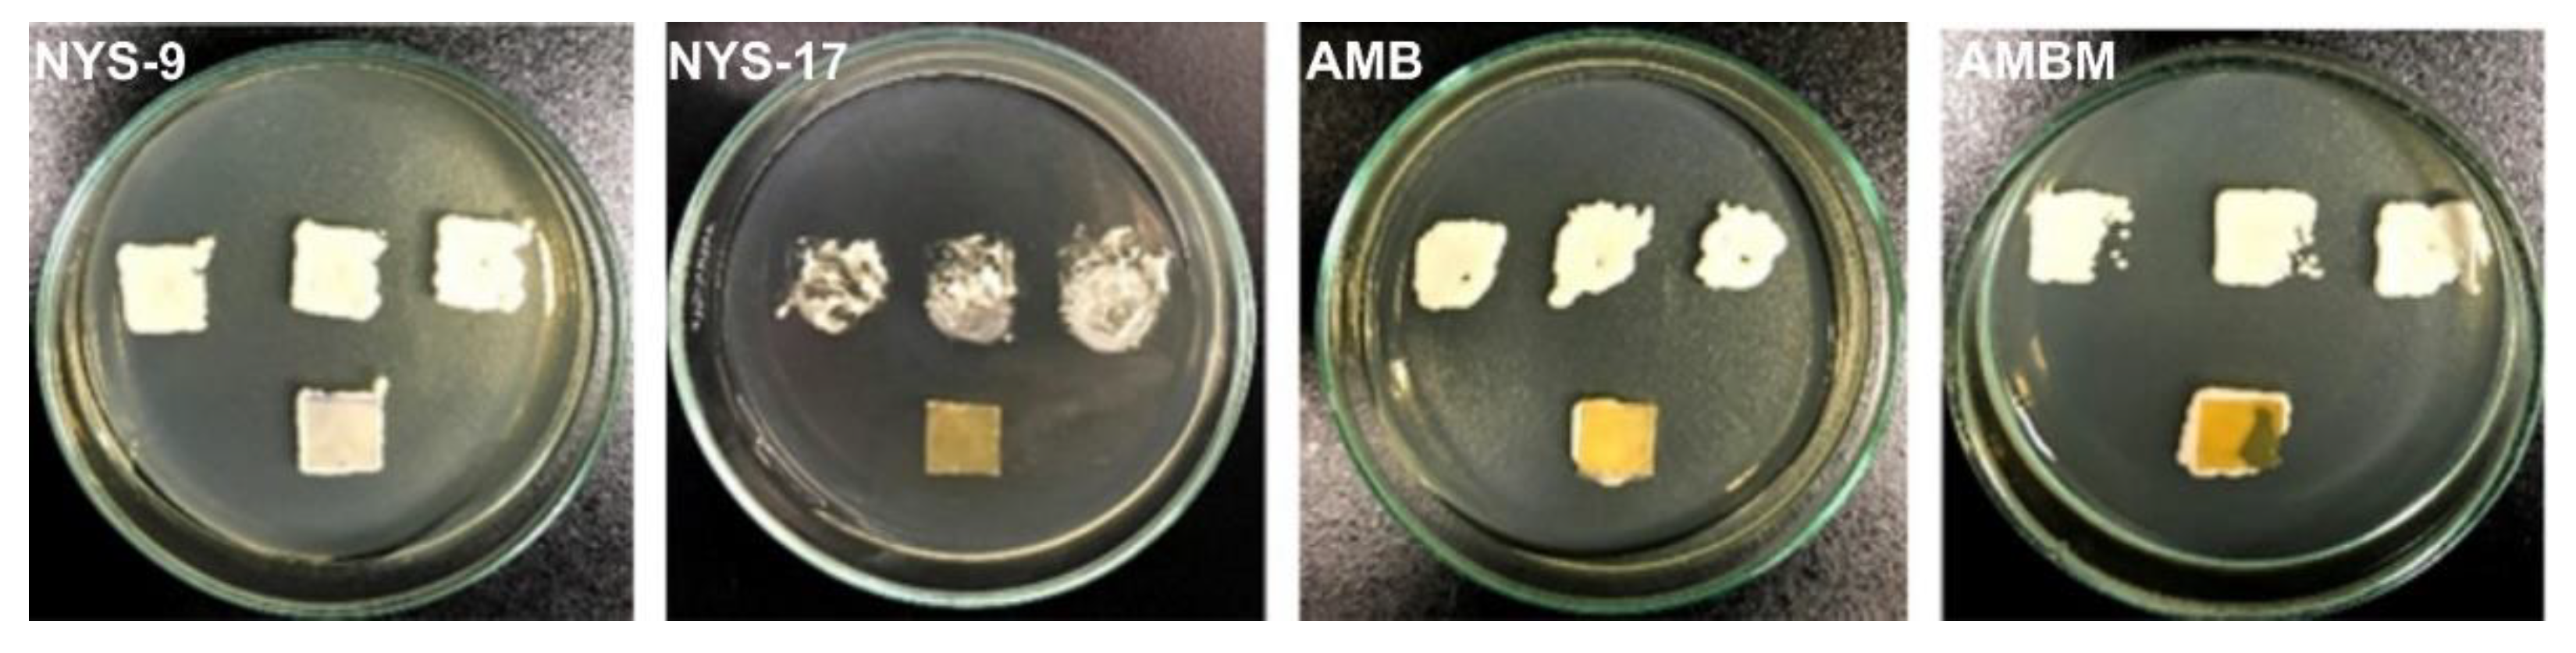

Polyhydroxyalkanoate/Antifungal Polyene Formulations with Monomeric Hydroxyalkanoic Acids for Improved Antifungal Efficiency
Abstract
1. Introduction
2. Results
2.1. Antifungal Properties of PHA Monomers, Nystatin and Amphothericin B
2.2. Mcl-PHA/Polyene Films Morphology and Microstructure
2.3. Polyene Release Kinetics from Mcl-PHA/Polyene Films
2.4. In Vitro Antifungal Activity of Polyenes Immbolised in mcl-PHA
2.5. Inhibition of C. albicans Biofilm Formation
3. Discussion
4. Materials and Methods
4.1. Mcl-PHA and Monomers Production
4.2. Preparation of mcl-PHA/Polyene Films
4.3. Characterization of mcl-PHA/Polyene Films
4.3.1. Scanning Electron Microscopy (SEM)
4.3.2. Differential Scanning Calorimetry (DSC) and Thermogravimetric Analysis (TGA)
4.3.3. Water Contact Angle (WCA)
4.3.4. Release Kinetics
4.4. In Vitro Antifungal Activity
4.5. Candida Biofilm Inhibition Test
4.6. Cytotoxicity Test
4.7. Statistical Analysis
5. Conclusions
Supplementary Materials
Author Contributions
Funding
Data Availability Statement
Conflicts of Interest
References
- Shahid, S.; Razzaq, S.; Farooq, R.; Nazli, Z.-I.-H. Polyhydroxyalkanoates: Next generation natural biomolecules and a solution for the world’s future economy. Int. J. Biol. Macromol. 2021, 166, 297–321. [Google Scholar] [CrossRef]
- Riaz, S.; Rhee, K.Y.; Park, S.J. Polyhydroxyalkanoates (PHAs): Biopolymers for Biofuel and Biorefineries. Polymers 2021, 13, 253. [Google Scholar] [CrossRef] [PubMed]
- Dietrich, K.; Dumont, M.-J.; Del Rio, L.F.; Orsat, V. Producing PHAs in the bioeconomy—Towards a sustainable bioplastic. Sustain. Prod. Consum. 2017, 9, 58–70. [Google Scholar] [CrossRef]
- Basnett, P.; Ravi, S.; Roy, I. Science and Principles of Biodegradable and Bioresorbable Medical Polymers; Zhang, X., Ed.; Woodhead Publishing: Sawston, UK, 2017; pp. 257–277. [Google Scholar]
- Narancic, T.; Cerrone, F.; Beagan, N.; O’Connor, K.E. Recent Advances in Bioplastics: Application and Biodegradation. Polymers 2020, 12, 920. [Google Scholar] [CrossRef]
- Guzik, M.; Witko, T.; Steinbüchel, A.; Wojnarowska, M.; Sołtysik, M.; Wawak, S. What Has Been Trending in the Research of Polyhydroxyalkanoates? A Systematic Review. Front. Bioeng. Biotechnol. 2020, 8, 959. [Google Scholar] [CrossRef] [PubMed]
- Sudesh, K.; Abe, H.; Doi, Y. Synthesis, structure and properties of polyhydroxyalkanoates: Biological polyesters. Prog. Polym. Sci. 2000, 25, 1503–1555. [Google Scholar] [CrossRef]
- Rai, R.; Roether, J.A.; Knowles, J.C.; Mordan, N.; Salih, V.; Locke, I.C.; Gordge, M.P.; McCormick, A.; Mohn, D.; Stark, W.J.; et al. Highly elastomeric poly(3-hydroxyoctanoate) based natural polymer composite for enhanced keratinocyte regeneration. Int. J. Polym. Mater. 2017, 66, 326–335. [Google Scholar] [CrossRef]
- Zhang, J.; Shishatskaya, E.; Volova, T.G.; da Silva, L.F.; Chen, G.-Q. Polyhydroxyalkanoates (PHA) for therapeutic applications. Mater. Sci. Eng. C 2018, 86, 144–150. [Google Scholar] [CrossRef]
- Lukasiewicz, B.; Basnett, P.; Nigmatullin, R.; Matharu, R.; Knowles, J.C.; Roy, I. Binary polyhydroxyalkanoate systems for soft tissue engineering. Acta Biomater. 2018, 71, 225–234. [Google Scholar] [CrossRef] [PubMed]
- Goswami, M.; Rekhi, P.; Debnath, M.; Ramakrishna, S. Microbial Polyhydroxyalkanoates Granules: An Approach Targeting Biopolymer for Medical Applications and Developing Bone Scaffolds. Molecules 2021, 26, 860. [Google Scholar] [CrossRef]
- Taylor, M.S.; Daniels, A.U.; Andriano, K.P.; Heller, J. Six bioabsorbable polymers:In vitro acute toxicity of accumulated degradation products. J. Appl. Biomater. 1994, 5, 151–157. [Google Scholar] [CrossRef]
- Gogolewski, S.; Jovanovic, M.; Perren, S.M.; Dillon, J.G.; Hughes, M.K. Tissue response and in vivo degradation of selected polyhydroxyacids: Polylactides (PLA), poly(3-hydroxybutyrate) (PHB), and poly(3-hydroxybutyrate-co-3-hydroxyvalerate) (PHB/VA). J. Biomed. Mat. Res. 1993, 27, 1135–1148. [Google Scholar] [CrossRef]
- Wu, A.C.; Grøndahl, L.; Jack, K.; Foo, M.X.; Trau, M.; Hume, D.A.; Cassady, A.I. Reduction of the in vitro pro-inflammatory response by macrophages to poly(3-hydroxybutyrate-co-3-hydroxyvalerate). Biomaterials 2006, 27, 4715–4725. [Google Scholar] [CrossRef]
- Bagdadi, A.V.; Safari, M.; Dubey, P.; Basnett, P.; Sofokleous, P.; Humphrey, E.; Locke, I.; Edirisinghe, M.; Terracciano, C.; Boccaccini, A.R.; et al. Poly(3-hydroxyoctanoate), a promising new material for cardiac tissue engineering. J. Tissue Eng. Regen. Med. 2018, 12, e495–e512. [Google Scholar] [CrossRef] [PubMed]
- Dinjaski, N.; Fernández-Gutiérrez, M.; Selvam, S.; Parra-Ruiz, F.J.; Lehman, S.M.; San Román, J.; García, E.; García, J.L.; García, A.J.; Prieto, M.A. PHACOS, a functionalized bacterial polyester with bactericidal activity against methicillin-resistant Staphylococcus aureus. Biomaterials 2014, 35, 14–24. [Google Scholar] [CrossRef] [PubMed]
- Panaitescu, D.M.; Lupescu, I.; Frone, A.N.; Chiulan, I.; Nicolae, C.A.; Tofan, V.; Stefaniu, A.; Somoghi, R.; Trusca, R. Medium Chain-Length Polyhydroxyalkanoate Copolymer Modified by Bacterial Cellulose for Medical Devices. Biomacromolecules 2017, 18, 3222–3232. [Google Scholar] [CrossRef]
- Radivojevic, J.; Skaro, S.; Senerovic, L.; Vasiljevic, B.; Guzik, M.; Kenny, S.T.; Maslak, V.; Nikodinovic-Runic, J.; O’Connor, K.E. Polyhydroxyalkanoate-based 3-hydroxyoctanoic acid and its derivatives as a platform of bioactive compounds. Appl. Microbiol. Biotechnol. 2015, 100, 161–172. [Google Scholar] [CrossRef] [PubMed]
- O’Connor, S.; Szwej, E.; Nikodinović-Runić, J.; O’Connor, A.; Byrne, A.T.; Devocelle, M.; O’Donovan, N.; Gallagher, W.M.; Babu, R.; Kenny, S.T.; et al. The anti-cancer activity of a cationic anti-microbial peptide derived from monomers of polyhydroxyalkanoate. Biomaterials 2013, 34, 2710–2718. [Google Scholar] [CrossRef]
- Szwej, E.; Devocelle, M.; Kenny, S.; Guzik, M.; O’Connor, S.; Nikodinovic-Runic, J.; Radivojevic, J.; Maslak, V.; Byrne, A.T.; Gallagher, W.M.; et al. The chain length of biologically produced ( R )-3-hydroxyalkanoic acid affects biological activity and structure of anti-cancer peptides. J. Biotechnol. 2015, 204, 7–12. [Google Scholar] [CrossRef]
- Bongomin, F.; Gago, S.; Oladele, R.O.; Denning, D.W. Global and Multi-National Prevalence of Fungal Diseases—Estimate Precision. J. Fungi 2017, 3, 57. [Google Scholar] [CrossRef] [PubMed]
- Kainz, K.; Bauer, M.A.; Madeo, F.; Carmona-Gutierrez, D. Fungal infections in humans: The silent crisis. Microb. Cell 2020, 7, 143–145. [Google Scholar] [CrossRef]
- Consortium OPATHY; Arastehfar, A.; Boekhout, T.; Butler, G.; De Cesare, G.B.; Dolk, E.; Gabaldón, T.; Hafez, A.; Hube, B. Recent trends in molecular diagnostics of yeast infections: From PCR to NGS. FEMS Microbiol. Rev. 2019, 43, 517–547. [Google Scholar] [CrossRef]
- McCarty, T.P.; Pappas, P.G. Invasive Candidiasis. Infect. Dis. Clin. N. Am. 2016, 30, 103–124. [Google Scholar] [CrossRef]
- Cavalheiro, M.; Teixeira, M.C. Candida Biofilms: Threats, Challenges, and Promising Strategies. Front. Med. 2018, 5, 28. [Google Scholar] [CrossRef]
- De Barros, P.P.; Rossoni, R.D.; De Souza, C.M.; Scorzoni, L.; Fenley, J.D.C.; Junqueira, J.C. Candida Biofilms: An Update on Developmental Mechanisms and Therapeutic Challenges. Mycopathologia 2020, 185, 415–424. [Google Scholar]
- Roilides, E.; Simitsopoulou, M.; Katragkou, A.; Walsh, T.J. How Biofilms Evade Host Defenses. Microbiol. Spectr. 2015, 3, 287–300. [Google Scholar] [CrossRef]
- Andes, D.; Nett, J.; Oschel, P.; Albrecht, R.; Marchillo, K.; Pitula, A. Development and Characterization of an In Vivo Central Venous Catheter Candida albicans Biofilm Model. Infect. Immun. 2004, 72, 6023–6031. [Google Scholar] [CrossRef]
- Eix, E.F.; Nett, J.E. How Biofilm Growth Affects Candida-Host Interactions. Front. Microbiol. 2020, 11, 1437. [Google Scholar] [CrossRef] [PubMed]
- Giles, C.; Lamont-Friedrich, S.J.; Michl, T.D.; Griesser, H.J.; Coad, B.R. The importance of fungal pathogens and antifungal coatings in medical device infections. Biotechnol. Adv. 2018, 36, 264–280. [Google Scholar] [CrossRef]
- Cavassin, F.B.; Baú-Carneiro, J.L.; Vilas-Boas, R.R.; Queiroz-Telles, F. Sixty years of Amphotericin B: An Overview of the Main Antifungal Agent Used to Treat Invasive Fungal Infections. Infect. Dis. Ther. 2021, 10, 115–147. [Google Scholar] [CrossRef]
- Zotchev, S.B. Polyene Macrolide Antibiotics and their Applications in Human Therapy. Curr. Med. Chem. 2003, 10, 211–223. [Google Scholar] [CrossRef]
- Lyu, X.; Zhao, C.; Hua, H.; Yan, Z. Efficacy of nystatin for the treatment of oral candidiasis: A systematic review and meta-analysis. Drug Des. Dev. Ther. 2016, 10, 1161–1171. [Google Scholar] [CrossRef]
- Gøtzsche, P.C.; Johansen, H.K. Nystatin prophylaxis and treatment in severely immunodepressed patients. Cochrane Database Syst. Rev. 2014, 2014, CD002033. [Google Scholar] [CrossRef]
- Blyth, C.C.; Barzi, F.; Hale, K.; Isaacs, D. Chemoprophylaxis of neonatal fungal infections in very low birthweight infants: Efficacy and safety of fluconazole and nystatin. J. Paediatr. Child Health 2012, 48, 846–851. [Google Scholar] [CrossRef]
- Pérez-Sayáns, M.; Beiro-Fuentes, R.; Otero-Rey, E.M.; Chamorro-Petronacci, C.M.; Gándara-Vila, P.; Somoza-Martín, J.M.; García-García, A.; Blanco-Carrión, A. Efficacy of different formulations of nystatin in an experimental model of oral candidiasis in sialoadenectomized rats. J. Dent. Sci. 2021, 16, 123–130. [Google Scholar] [CrossRef] [PubMed]
- Taudorf, E.H.; Jemec, G.B.E.; Hay, R.J.; Saunte, D.M.L. Cutaneous candidiasis—an evidence-based review of topical and systemic treatments to inform clinical practice. J. Eur. Acad. Dermatol. Venereol. 2019, 33, 1863–1873. [Google Scholar] [CrossRef]
- Saravolatz, L.D.; Ostrosky-Zeichner, L.; Marr, K.A.; Rex, J.H.; Cohen, S.H. Amphotericin B: Time for a New “Gold Standard”. Clin. Infect. Dis. 2003, 37, 415–425. [Google Scholar] [CrossRef]
- Sterling, T.R.; Merz, W.G. Resistance to amphotericin B: Emerging clinical and microbiological patterns. Drug Resist. Updat. 1998, 1, 161–165. [Google Scholar] [CrossRef]
- Hamill, R.J. Amphotericin B Formulations: A Comparative Review of Efficacy and Toxicity. Drugs 2013, 73, 919–934. [Google Scholar] [CrossRef] [PubMed]
- Bassi, R.C.; Boriollo, M.F. Amphotericin B, fluconazole, and nystatin as development inhibitors of Candida albicans biofilms on a dental prosthesis reline material: Analytical models in vitro. J. Prosthet. Dent. 2020. [Google Scholar] [CrossRef] [PubMed]
- Maiolo, E.M.; Tafin, U.F.; Borens, O.; Trampuz, A. Activities of Fluconazole, Caspofungin, Anidulafungin, and Amphotericin B on Planktonic and Biofilm Candida Species Determined by Microcalorimetry. Antimicrob. Agents Chemother. 2014, 58, 2709–2717. [Google Scholar] [CrossRef]
- Ren, Q.; Ruth, K.; Thöny-Meyer, L.; Zinn, M. Enatiomerically pure hydroxycarboxylic acids: Current approaches and future perspectives. Appl. Microbiol. Biotechnol. 2010, 87, 41–52. [Google Scholar] [CrossRef]
- Ruth, K.; Grubelnik, A.; Hartmann, R.; Egli, T.; Zinn, M.; Ren, Q. Efficient Production of (R)-3-Hydroxycarboxylic Acids by Biotechnological Conversion of Polyhydroxyalkanoates and Their Purification. Biomacromolecules 2007, 8, 279–286. [Google Scholar] [CrossRef]
- Yañez, L.; Conejeros, R.; Vergara-Fernández, A.; Scott, F. Beyond Intracellular Accumulation of Polyhydroxyalkanoates: Chiral Hydroxyalkanoic Acids and Polymer Secretion. Front. Bioeng. Biotechnol. 2020, 8, 248. [Google Scholar] [CrossRef]
- Latgé, J.-P. Aspergillus fumigatus and Aspergillosis. Clin. Microbiol. Rev. 1999, 12, 310–350. [Google Scholar] [CrossRef] [PubMed]
- Binder, U.; Lass-Flörl, C. New insights into invasive aspergillosis--from the pathogen to the disease. Curr. Pharm. Des. 2013, 19, 3679–3688. [Google Scholar] [CrossRef] [PubMed]
- Hadrich, I.; Makni, F.; Neji, S.; Abbes, S.; Cheikhrouhou, F.; Trabelsi, H.; Sellami, H.; Ayadi, A. Invasive Aspergillosis: Resistance to Antifungal Drugs. Mycopathologia 2012, 174, 131–141. [Google Scholar] [CrossRef]
- Kaur, S.; Singh, S. Biofilm formation byAspergillus fumigatus. Med Mycol. 2013, 52, 1–8. [Google Scholar] [CrossRef]
- Moriello, K.A.; Coyner, K.; Paterson, S.; Mignon, B. Diagnosis and treatment of dermatophytosis in dogs and cats.: Clinical consensus guidelines of the World Association for Veterinary Dermatology. Vet. Dermatol. 2017, 28, 266-e68. [Google Scholar] [CrossRef] [PubMed]
- AL-Khikani, F. Dermatophytosis a worldwide contiguous fungal infection: Growing challenge and few solutions. Biomed. Biotechnol. Res. J. 2020, 4, 117–122. [Google Scholar]
- Zhan, P.; Liu, W. The Changing Face of Dermatophytic Infections Worldwide. Mycopathologia 2016, 182, 77–86. [Google Scholar] [CrossRef]
- Santos, R.; Ricardo, E.; Branco, R.; Azevedo, M.M.; Rodrigues, A.G.; Pina-Vaz, C. Unveiling the Synergistic Interaction Between Liposomal Amphotericin B and Colistin. Front. Microbiol. 2016, 7, 1439. [Google Scholar] [CrossRef][Green Version]
- Chudzik, B.; Bonio, K.; Dabrowski, W.; Pietrzak, D.; Niewiadomy, A.; Olender, A.; Malodobry, K.; Gagoś, M. Synergistic antifungal interactions of amphotericin B with 4-(5-methyl-1,3,4-thiadiazole-2-yl) benzene-1,3-diol. Sci. Rep. 2019, 9, 1–14. [Google Scholar] [CrossRef]
- Sugar, A.M. Use of amphotericin B with azole antifungal drugs: What are we doing? Antimicrob. Agents Chemother. 1995, 39, 1907–1912. [Google Scholar] [CrossRef] [PubMed][Green Version]
- Hargreaves, P.L.; Nguyen, T.-S.; Ryan, R.O. Spectroscopic studies of amphotericin B solubilized in nanoscale bilayer membranes. Biochim. et Biophys. Acta (BBA) Biomembr. 2006, 1758, 38–44. [Google Scholar] [CrossRef] [PubMed][Green Version]
- Kagan, S.; Ickowicz, D.; Shmuel, M.; Altschuler, Y.; Sionov, E.; Pitusi, M.; Weiss, A.; Farber, S.; Domb, A.J.; Polacheck, I. Toxicity Mechanisms of Amphotericin B and Its Neutralization by Conjugation with Arabinogalactan. Antimicrob. Agents Chemother. 2012, 56, 5603–5611. [Google Scholar] [CrossRef] [PubMed]
- Gajdošová, M.; Vetchý, D.; Doležel, P.; Gajdziok, J.; Landová, H.; Muselík, J.; Zeman, J.; Knotek, Z.; Hauptman, K.; Jekl, V. Evaluation of mucoadhesive oral films containing nystatin. J. Appl. Biomed. 2016, 14, 247–256. [Google Scholar] [CrossRef]
- Hombach, J.; Palmberger, T.F.; Bernkop-Schnürch, A. Development and In Vitro Evaluation of a Mucoadhesive Vaginal Delivery System for Nystatin. J. Pharm. Sci. 2009, 98, 555–564. [Google Scholar] [CrossRef] [PubMed]
- Acosta, S.; Chiralt, A.; Santamarina, P.; Rosello, J.; González-Martínez, C.; Cháfer, M. Antifungal films based on starch-gelatin blend, containing essential oils. Food Hydrocoll. 2016, 61, 233–240. [Google Scholar] [CrossRef]
- Ziani, K.; Fernández-Pan, I.; Royo, M.; Maté, J.I. Antifungal activity of films and solutions based on chitosan against typical seed fungi. Food Hydrocoll. 2009, 23, 2309–2314. [Google Scholar] [CrossRef]
- Munhuweyi, K.; Caleb, O.J.; Lennox, C.L.; van Reenen, A.J.; Opara, U.L. In vitro and in vivo antifungal activity of chitosan-essential oils against pomegranate fruit pathogens. Postharvest Biol. Technol. 2017, 129, 9–22. [Google Scholar] [CrossRef]
- Trinetta, V.; McDaniel, A.; Batziakas, K.G.; Yucel, U.; Nwadike, L.; Pliakoni, E. Antifungal packaging film to maintain quality and control postharvest diseases in strawberries. Antibiotics 2020, 9, 618. [Google Scholar] [CrossRef]
- Hammoudi, N.; Cherif, H.Z.; Borsali, F.; Benmansour, K.; Meghezzi, A. Preparation of active antimicrobial and antifungal alginate-montmorillonite/lemon essential oil nanocomposite films. Mater. Technol. 2020, 35, 383–394. [Google Scholar] [CrossRef]
- Minghetti, P.; Cilurzo, F.; Casiraghi, A.; Molla, F.A.; Montanari, L. Dermal Patches for the Controlled Release of Miconazole: Influence of the Drug Concentration on the Technological Characteristics. Drug Dev. Ind. Pharm. 1999, 25, 679–684. [Google Scholar] [CrossRef]
- Croxtall, J.D.; Plosker, G.L. Sertaconazole: A review of its use in the management of superficial mycoses in dermatology and gynaecology. Drugs 2009, 69, 339. [Google Scholar] [CrossRef] [PubMed]
- Zan, P.; Than, A.; Duong, P.K.; Song, J.; Xu, C.; Chen, P. Antimicrobial Microneedle Patch for Treating Deep Cutaneous Fungal Infection. Adv. Ther. 2019, 2, 1900064. [Google Scholar] [CrossRef]
- Ansari, N.F.; Annuar, M.S.M.; Murphy, B.P. A porous medium-chain-length poly(3-hydroxyalkanoates)/hydroxyapatite composite as scaffold for bone tissue engineering. Eng. Life Sci. 2016, 17, 420–429. [Google Scholar] [CrossRef]
- Malagurski, I.; Frison, R.; Maurya, A.K.; Neels, A.; Andjelkovic, B.; Senthamaraikannan, R.; Babu, R.P.; O’Connor, K.E.; Witko, T.; Solarz, D.; et al. Polyhydroxyoctanoate films reinforced with titanium dioxide microfibers for biomedical application. Mater. Lett. 2021, 285, 129100. [Google Scholar] [CrossRef]
- Basnett, P.; Ching, K.Y.; Stolz, M.; Knowles, J.C.; Boccaccini, A.R.; Smith, C.L.; Locke, I.C.; Roy, I. Aspirin-loaded P(3HO)/P(3HB) blend films: Potential materials for biodegradable drug-eluting stents. Bioinspired Biomim. Nanobiomater. 2013, 2, 141–153. [Google Scholar] [CrossRef]
- Douglas, L. Candida biofilms and their role in infection. Trends Microbiol. 2003, 11, 30–36. [Google Scholar] [CrossRef]
- Beauvais, A.; Latgé, J.-P. Aspergillus Biofilm In Vitro and In Vivo. Microbiol. Spectr. 2015, 3. [Google Scholar] [CrossRef]
- Potera, C.; Han, J.; Craighead, H.G. MICROBIOLOGY:Forging a Link Between Biofilms and Disease. Science 1999, 283, 1837–1839. [Google Scholar] [CrossRef]
- Sofińska, K.; Barbasz, J.; Witko, T.; Dryzek, J.; Haraźna, K.; Witko, M.; Kryściak-Czerwenka, J.; Guzik, M. Structural, topographical, and mechanical characteristics of purified polyhydroxyoctanoate polymer. J. Appl. Polym. Sci. 2019, 136, 47192. [Google Scholar] [CrossRef]
- Marques, M.R.C.; Loebenberg, R.; Almukainzi, M. Simulated Biological Fluids with Possible Application in Dissolution Testing. Dissolution Technol. 2011, 18, 15–28. [Google Scholar] [CrossRef]
- Gagoś, M.; Koper, R.; Gruszecki, W.I. Spectrophotometric analysis of organisation of dipalmitoylphosphatidylcholine bilayers containing the polyene antibiotic amphotericin B. Biochim. et Biophys. Acta (BBA) Biomembr. 2001, 1511, 90–98. [Google Scholar] [CrossRef]
- Lupan, L.; Bandula, R.; Vasilescu, M.; Bercu, C. Spectroscopic study on nystatin conformational modifications generated by its interaction with the solvent. Anal. Bioanal. Chem. 1996, 355, 409–411. [Google Scholar] [CrossRef]
- Odds, F.C. Synergy, antagonism, and what the chequerboard puts between them. J. Antimicrob. Chemother. 2003, 52, 1. [Google Scholar] [CrossRef]
- Bjarnsholt, T.; Alhede, M.; Jensen, P.Ø.; Nielsen, A.K.; Johansen, H.K.; Homøe, P.; Høiby, N.; Givskov, M.C.; Kirketerp-Møller, K. Antibiofilm Properties of Acetic Acid. Adv. Wound Care 2015, 4, 363–372. [Google Scholar] [CrossRef]
- Hansen, M.B.; Nielsen, S.E.; Berg, K. Re-examination and further development of a precise and rapid dye method for measuring cell growth/cell kill. J. Immunol. Methods 1989, 119, 203–210. [Google Scholar] [CrossRef]

| Compound | Candida Albicans | Candida Parapsilosis | Aspergillus Fumigatus | Microsporum Gypseum | Trichophyton Mentagrophytes | MRC-5 |
|---|---|---|---|---|---|---|
| Nys | 1.00 | 1.00 | 4.00 | 4.00 | 8.00 | 25.00 |
| AmB | 0.25 | 0.25 | 2.00 | 2.00 | 0.50 | 4.00 |
| C8-OH | 500 | >500 | >500 | 250 | 500 | 1000 |
| C10-OH | 250 | 250 | 500 | 250 | 250 | 800 |
| C10-OH/AmB | 6.25/0.125 | 15.60/0.125 | 6.25/1 | 15.60/1 | / 1 | 500–800 |
| Sample | mcl-PHA [g] | Nys [g] | AmB [g] | CHCl3 [mL] | % wt Polyene per Film Solution |
|---|---|---|---|---|---|
| PHA | 1.0 | - | - | 6 | - |
| PHA/Nys | |||||
| 1 | 0.50 | 0.01 | - | 6.00 | 0.10 |
| 2 | 1.00 | 0.02 | - | 12.00 | 0.10 |
| 3 | 2.00 | 0.20 | - | 12.00 | 0.10 |
| 4 (NYS-9) | 0.50 | 0.01 | - | 3.00 | 0.20 |
| 5 | 2.00 | 0.30 | - | 12.00 | 1.50 |
| 6 (NYS-17) | 1.00 | 0.20 | - | 6.00 | 2.00 |
| 7 | 1.00 | 0.20 | - | 3.00 | 3.50 |
| PHA/AmB | |||||
| 8 (AMB) | 0.50 | - | 0.006 | 2.50 | 0.10 |
| 9 | 0.40 | - | 0.04 | 2.50 | 1.00 |
| 10 (AMB-M) 1 | 0.40 | - | 0.04 | 2.50 | 1.00 |
Publisher’s Note: MDPI stays neutral with regard to jurisdictional claims in published maps and institutional affiliations. |
© 2021 by the authors. Licensee MDPI, Basel, Switzerland. This article is an open access article distributed under the terms and conditions of the Creative Commons Attribution (CC BY) license (https://creativecommons.org/licenses/by/4.0/).
Share and Cite
Pekmezovic, M.; Kalagasidis Krusic, M.; Malagurski, I.; Milovanovic, J.; Stępień, K.; Guzik, M.; Charifou, R.; Babu, R.; O’Connor, K.; Nikodinovic-Runic, J. Polyhydroxyalkanoate/Antifungal Polyene Formulations with Monomeric Hydroxyalkanoic Acids for Improved Antifungal Efficiency. Antibiotics 2021, 10, 737. https://doi.org/10.3390/antibiotics10060737
Pekmezovic M, Kalagasidis Krusic M, Malagurski I, Milovanovic J, Stępień K, Guzik M, Charifou R, Babu R, O’Connor K, Nikodinovic-Runic J. Polyhydroxyalkanoate/Antifungal Polyene Formulations with Monomeric Hydroxyalkanoic Acids for Improved Antifungal Efficiency. Antibiotics. 2021; 10(6):737. https://doi.org/10.3390/antibiotics10060737
Chicago/Turabian StylePekmezovic, Marina, Melina Kalagasidis Krusic, Ivana Malagurski, Jelena Milovanovic, Karolina Stępień, Maciej Guzik, Romina Charifou, Ramesh Babu, Kevin O’Connor, and Jasmina Nikodinovic-Runic. 2021. "Polyhydroxyalkanoate/Antifungal Polyene Formulations with Monomeric Hydroxyalkanoic Acids for Improved Antifungal Efficiency" Antibiotics 10, no. 6: 737. https://doi.org/10.3390/antibiotics10060737
APA StylePekmezovic, M., Kalagasidis Krusic, M., Malagurski, I., Milovanovic, J., Stępień, K., Guzik, M., Charifou, R., Babu, R., O’Connor, K., & Nikodinovic-Runic, J. (2021). Polyhydroxyalkanoate/Antifungal Polyene Formulations with Monomeric Hydroxyalkanoic Acids for Improved Antifungal Efficiency. Antibiotics, 10(6), 737. https://doi.org/10.3390/antibiotics10060737

